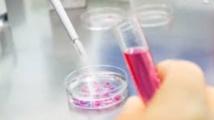

Autres articles
-
Etre footballeuse avec un bébé n'est plus une rareté
-
La mer Méditerranée a enregistré dimanche une température record pour un mois de juin
-
Des experts américains veulent supprimer des vaccins un composant critiqué par les antivax
-
A Nairobi, des femmes DJ veulent occuper le devant de la scène
-
Japon : Un ours force à l'annulation de vols
Des chercheurs américains ont découvert, en scrutant les ADN de près de 4.000 personnes, quatre mutations rares d'un gène qui réduisent de 40% le risque de maladie coronarienne.
Cette découverte pourrait permettre de mettre au point de nouveaux traitements, estiment ces scientifiques dont les travaux sont publiés dans la revue américaine New England Journal of Medicine.
Les graisses circulant dans le sang sont liées aux risques de maladies cardio-vasculaires. Elles prennent plusieurs formes, dont le mauvais cholestérol (LDL), le bon cholestérol (HDL) et les triglycérides.
Les chercheurs ont ici mis l'accent sur le rôle des triglycérides: en quantités trop importantes dans le sang, elles contribuent pour beaucoup aux maladies cardio-vasculaires. En revanche, un taux trop bas de bon cholestérol (HDL) n'est pas aussi néfaste qu'on le pensait.
"De récents essais cliniques non concluants de molécules pour accroître le bon cholestérol, combinés à nos résultats génétiques, sont en train de bouleverser des décennies de certitudes médicales", estime le Dr Sekar Kathiresan, directeur du service de cardiologie préventive au Massachusetts General Hospital (nord-est), principal auteur de cette étude.
On pensait depuis longtemps qu'un taux de bon cholestérol (HDL) trop faible était un facteur important dans les maladies cardio- vasculaires, poursuit le chercheur, mais "nos données génétiques indiquent que la véritable cause ne serait pas un HDL trop bas, mais bien des taux élevés de triglycérides", ajoute-t-il.
Alors que le rôle joué par le mauvais cholestérol à des niveaux excessifs a déjà été clairement établi dans les pathologies coronariennes, celui du bon cholestérol à des niveaux insuffisants ou des triglycérides restent obscures, selon ces scientifiques.
Mais cette recherche génétique a montré que les personnes porteuses d'une mutation du gène appelé "APOC3" avaient des niveaux de triglycérides de près de 40% plus bas.
Ainsi, les niveaux sanguins normaux de ces lipides sont normalement de moins de 150 milligrammes par décilitre (mg/dL). Chez les sujets ayant une mutation du gène APOC3, les taux de triglycérides se situent autour de 85 mg/dL, réduisant d'autant le risque cardio-vasculaire, selon les auteurs.